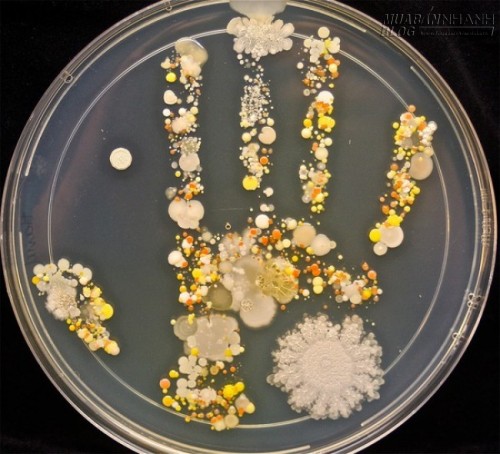

Ngã ngửa vì một loạt vi khuẩn ăn ngủ nghỉ trên bàn tay bạn
Ngã ngửa vì một loạt vi khuẩn ăn ngủ nghỉ trên bàn tay bạn, 39958, Nguyễn Thu Hương Blog MuaBanNhanh
Đăng bởi
Nguyễn Thu Hương
| 09/06/2015 | 2292
Các chuyên gia khuyến cáo, việc lười rửa tay sẽ khiến những vi khuẩn có hại ngày một bám rễ và gây hại cho cơ thể con người.
Mới đây, Tasha Sturm - một kỹ thuật viên phòng thí nghiệm tại California (Mỹ) đã công bố bức ảnh về cuộc sống những vi khuẩn thường đang cư trú trên bàn tay chúng ta.
Để có thể hoàn thành tác phẩm này, cô đã yêu cầu đứa con trai 8 tuổi của mình mới đi chơi ở ngoài về nắm chặt tay vào một miếng gel chuyên dụng trong việc cấy vi khuẩn. Miếng gel này sẽ được Sturm ủ trong vài ngày để vi khuẩn phát triển.
Hình ảnh vi khuẩn "nở hoa" trên bàn tay của một cậu bé 8 tuổi mới ở ngoài chơi về.
Kết quả là, cô thu được không ít các loài vi khuẩn với đặc điểm màu sắc vô cùng hấp dẫn. Sturm cho biết, có những loại vi khuẩn tốt cho cơ thể, nhưng cũng có vi khuẩn có thể khiến bạn đổ bệnh bất cứ lúc nào. Việc rửa tay thường xuyên với xà phòng sẽ phần nào giúp đẩy lùi những vi khuẩn làm tổ trên tay chúng ta.
Cùng điểm lại những loại vi khuẩn có thể đang trú ngụ nơi bàn tay của bạn qua bài viết dưới đây.
1. Salmonella
Salmonella là một chi vi khuẩn hình que thuộc họ Enterobacteriaceae - cùng họ với vi khuẩn E.coli nổi tiếng gây bệnh tiêu chảy. Salmonella được tìm thấy trên khắp thế giới, chúng là nguyên nhân gây nên các bệnh như sốt thương hàn, sốt rét và ngộ độc thực phẩm.

Loại vi khuẩn này thường được tìm thấy ở trứng sống, thịt gia cầm nấu chưa chín, rau sống... và lây truyền nhanh chóng khi một người ăn phải đồ ăn có nhiễm khuẩn hay tiếp xúc với chất thải từ động vật/người nhiễm bệnh. Chỉ cần Salmonella ngụ trên tay là bạn hoàn toàn có thể "ăn" chúng bất cứ lúc nào.
Theo các chuyên gia, Salmonella là thủ phạm gây ra 93,8 triệu ca ngộ độc trên thế giới mỗi năm. Theo một báo cáo năm 2011 của Trung tâm quản lý dịch bệnh Mỹ thì có hơn 1 triệu người Mỹ bị nhiễm Salmonella mỗi năm trong đó có khoảng 20.000 người phải nhập viện và có gần 400 ca tử vong.

Triệu chứng của bệnh nhân nhiễm Salmonella là tiêu chảy, sốt và đau bụng trong vòng 8-12h sau khi ăn thức ăn nhiễm khuẩn.
Trong một số trường hợp ở trẻ con và người già, bệnh nhân có thể bị mất nước dẫn đến những biến chứng nặng hơn. Salmonella có thể được phòng tránh bằng cách vệ sinh tay sạch sẽ.
2. Listeria
Vi khuẩn Listeria có thể dễ dàng được tìm thấy trong tự nhiên như trong đất, phân súc vật, nước thải, bùn lầy, rau hỏng, đặc biệt là trong lớp cỏ xanh chưa được phơi khô.
Khác với các bạn đồng loại, Listeria có khả năng phát triển ngay cả trong môi trường có nhiệt độ thấp như trong tủ lạnh nhưng sẽ sinh sôi nảy nở nhất ở môi trường 45 độ C.
Vi khuẩn từ đường tiêu hóa xâm nhập vào máu và các mô của người nhiễm vi khuẩn, từ đó di chuyển tới tế bào mẫn cảm và nhân lên nhiều lần. Người có nguy cơ cao mắc bệnh là trẻ sơ sinh, người trung niên, người bị tổn thương hệ miễn dịch và phụ nữ có thai.

Listeria có thể gây viêm dạ dày-ruột, cùng với các triệu chứng giống như cảm cúm. Trong một số trường hợp đặc biệt, chúng có thể gây nhiễm trùng huyết và thậm chí là viêm màng não. Nếu không được can thiệp kịp thời, khả năng bệnh nhân tử vong khá cao.
Lời khuyên được đưa ra để phòng tránh nhiễm virus Listeria là đun nấu kĩ thức ăn và rửa tay sạch để tránh lây nhiễm virus qua đường thực phẩm.
3. Escherichia Coli ( E.coli)
Còn được gọi là vi khuẩn đại tràng, E.coli là một trong những loài vi khuẩn chính kí sinh trong đường ruột các loài động vật máy nóng. Mặc dù là một vi khuẩn cần thiết cho quá trình tiêu hóa thức ăn, E.coli cũng có thể biến thành kẻ thù của cơ thể khi gây bệnh tiêu chảy.

Những chủng đột biến của E.coli mang những đặc tính thực sự nguy hiểm và trở thành một loại vi khuẩn đáng gờm đối với sức khỏe con người. E.coli có thể gây tiêu chảy, sốt, nặng hơn có thể gây rối loạn máu và suy thận.
Loại vi khuẩn này lây truyền qua đường phân - tay - miệng. Chúng truyền từ phân qua đường trung gian là bàn tay, thức ăn, nước uống… và được đưa vào cơ thể bằng đường miệng.

Chúng cũng có thể tồn tại trên thịt không nấu chín và nước sông nhiễm khuẩn. Chính vì thế mà một khuyến cáo quan trọng trong việc phòng tránh E.coli là phải rửa tay kĩ trước khi ăn.
4. Staphylococcus aureus
Staphylococcus aureus hay tụ cầu vàng là một loài tụ cầu khuẩn Gram và là nguyên nhân thông thường nhất gây nhiễm khuẩn trong số các loài tụ cầu. Chúng thường được tìm thấy dưới lớp da, tóc cũng như trong mũi và họng của người và động vật.

Staphulococcus có thể gây ra ngộ độc thực phẩm do chế biến thực phẩm không an toàn và thực phẩm không được bảo quản kĩ càng. Ở nhiệt độ phòng, chúng sinh sản nhanh chóng và sản xuất ra một loại chất độc có thể gây bệnh ở người.
Nguyên nhân phổ biến nhất của ngộ độc do Staphylococcus là do chế biến thức ăn với bàn tay trần và không đun nấu chín kĩ sau đó. Vi khuẩn này sẽ theo đường tay truyền qua các loại thực phẩm như salad, các loại bánh mỳ hay sandwiches… và theo vào cơ thể con người.

Do vậy, ngoài việc giữ thực phẩm sạch và tiệt trùng thì bạn cần đảm bảo tay phải sạch trước khi chế biến thức ăn bởi đây được cho là một trong những cách phòng chống vi khuẩn này.
5. Bacillus (trực khuẩn)
Bacillus là một chi gồm các vi khuẩn hình que thuộc về họ Bacillaceae. Khác với đa số vi khuẩn thuộc chi này là lợi khuẩn thì một số chủng khuẩn Bacillus cereus lại có thể gây ngộ độc thực phẩm.

Vi khuẩn này sản sinh ra hai loại độc tố: độc tố tiêu chảy và độc tố gây nôn mửa. Trong đó độc tố gây tiêu chảy sẽ làm hủy hoại biểu bì và niêm mạc ruột, thậm chí dẫn đến tử vong còn độc tố gây nôn mửa lại có sức sống cao và không bị phân hủy bởi nhiệt độ cao hay dịch dạ dày.
Bacillus cereus thường có trong đất và đôi khi trong các loại thực phẩm từ các loài hoa màu mọc gần mặt đất như cây đậu, ngũ cốc và các loại gia vị.

Theo đó, dù được nấu nướng đầy đủ nhưng các loại thức ăn này vẫn chứa mầm bệnh Bacillus cereus. Vi khuẩn này có thể phát triển trong môi trường ẩm ướt, phát tán thông qua bàn tay khi chế biến và phục vụ đồ ăn.
Vì vậy, lời khuyên của chuyên gia trong việc phòng tránh lây nhiễm Bacillus cereus là giữ đồ ăn nguội trong tủ lạnh đi kèm với rửa tay sạch sẽ trước/sau khi nấu ăn.
Nguồn: Mayoclinic, Wikipedia
Nguyễn Thu Hương Chưa xác định sản phẩm bán chạy, tiêu điểm.
Ngã ngửa vì một loạt vi khuẩn ăn ngủ nghỉ trên bàn tay bạn | Cộng đồng
Đăng bởi Nguyễn Thu Hương













